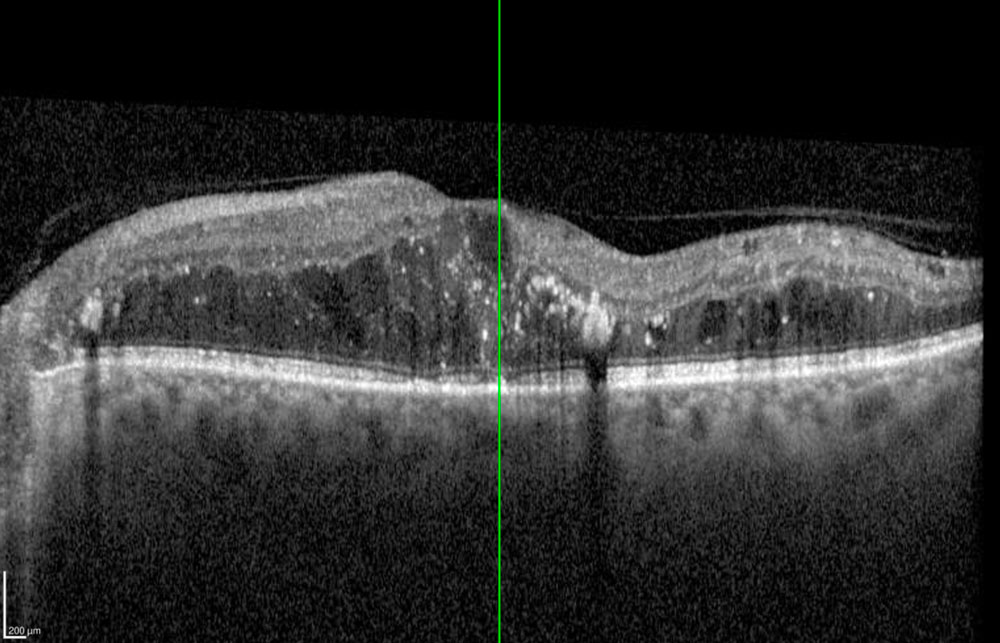

Rétinopathie diabétique
Definition
La rétinopathie diabétique est une complication microvasculaire du diabète chronique.
Elle résulte d’une altération des capillaires rétiniens entraînant des hémorragies, exsudats, œdèmes et néovaisseaux.
C’est une cause majeure de malvoyance dans le monde.
Informations
SIGNES CLINIQUES
- Longtemps asymptomatique.
- Baisse progressive de la vision, surtout en cas d’œdème maculaire.
- Vision floue, taches sombres.
EXAMENS COMPLéMENTAIRES
- Fond d’œil : examen de référence pour dépister microanévrismes, hémorragies, néovaisseaux.
- OCT : évaluation de l’œdème maculaire.
- Angiographie fluorescéinique : cartographie des zones ischémiques.
PRISE EN CHARGE
- Équilibre glycémique, tensionnel et lipidique : essentiel pour ralentir l’évolution.
- Laser panrétinien : en cas de prolifération néovasculaire.
- Injections intravitréennes : anti-VEGF ou corticoïdes pour l’œdème maculaire.
- Vitrectomie : en cas d’hémorragie intravitréenne persistante ou de décollement tractionnel de rétine.
complications possibles
- Cécité en cas de forme proliférante non traitée.
- Œdème maculaire chronique.
quand consulter ?
- Dépistage systématique annuel chez tout diabétique.
- Consultation urgente en cas de baisse rapide de vision.
FAQ – Rétinopathie diabétique
1. Tous les diabétiques développent-ils une rétinopathie ?
Non, mais le risque augmente avec la durée et le déséquilibre du diabète.
2. Peut-on récupérer la vision perdue ?
Non, mais le traitement permet de stabiliser et d’éviter l’aggravation.
3. Quelle fréquence de suivi ?
Au moins une fois par an, plus en cas de lésions évolutives.
4. Quels traitements existent ?
Laser, injections, chirurgie vitréo-rétinienne.
5. L’alimentation joue-t-elle un rôle ?
Oui, un bon équilibre glycémique ralentit l’évolution.
Vous n’avez pas trouvé la réponse à votre question ?
Utilisez l’espace Commentaires ci-dessous pour poser votre question.
Nous prendrons le temps de vous répondre directement, et votre demande pourra aussi être utile à d’autres patients.

0 commentaires